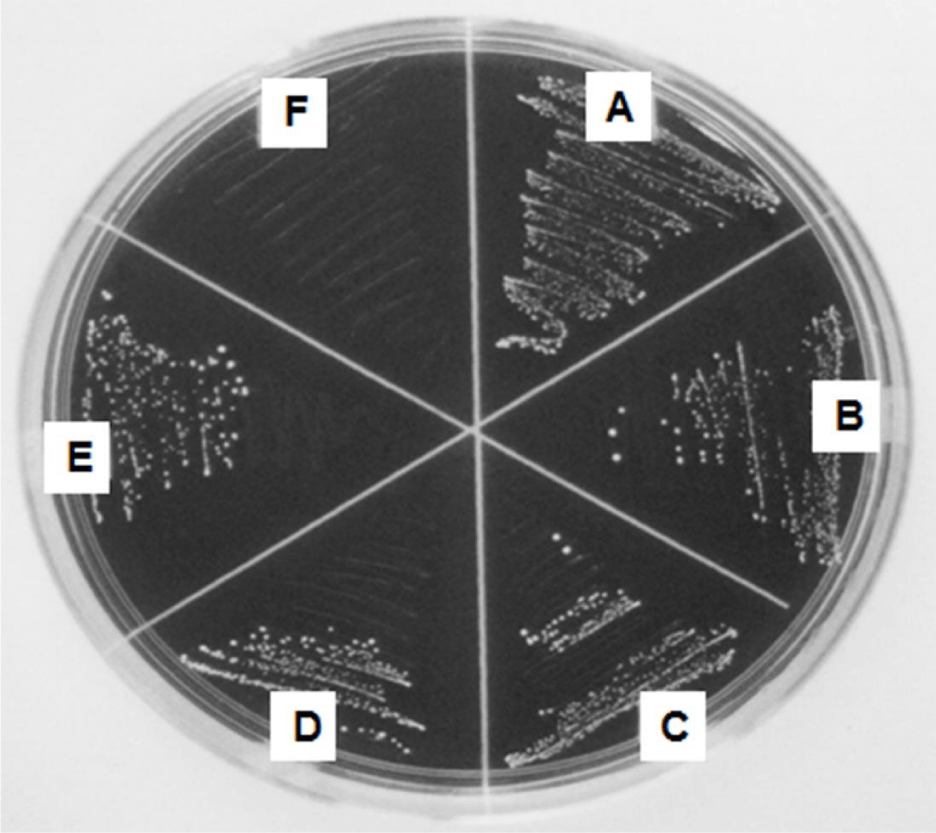

Research Article
Biofilm Models for Evaluation of Antibacterial Agents for Inhibition of Plaque Growth
Moon M. Kim*
Department of Applied Chemistry, Dong-Eui University, Busan, 614-714, Republic of Korea
*Address for Correspondence: Moon-Moo Kim, Department of Applied Chemistry, Dong-Eui University, Busan, 614-714, Republic of Korea, Tel: +825-189-011-11; Fax: +825-189-026-20; E-mail: mmkim@deu.ac.kr
Dates: 23 November 2017; Approved: 10 December 2017; Published: 13 December 2017
Citation this article: Kim MM. Biofilm Models for Evaluation of Antibacterial Agents for Inhibition of Plaque Growth. Sci J Biol. 2017;1(1): 019-024.
Copyright: © 2017 Kim MM. This is an open access article distributed under the Creative Commons Attribution License, which permits unrestricted use, distribution, and reproduction in any medium, provided the original work is properly cited.
Keywords: Streptococcus mutans; Dextran; Biofilm; Hydroxyapatite
Abstract
Although a variety of antimicrobials have been added to oral care to remove the plaque known as a major cause of caries, it is impossible to inhibit the growth of plaque, a kind of biofilm, because of their low penetration into biofilm. The purpose of this study is to investigate the effect of essential oils on growth of plaque biofilm using several biofilm developed as in vitro model. Methods: various kinds of biofilm simulating a natural oral biofilm on glass rod and hydroxyapatite were designed to compare the anti-biofilm effect of essential oils with that of antibacterial compounds. The effects of essential oils such as thymol, eugenol and clove oil on biofilm formed by Streptococcus mutans were compared with that of triclosan used as a positive control. The essential oils exhibited an antibacterial effect on Streptococcus mutans in dextran biofilm in addition to antibacterial effect in short time. In particular, thymol showed a higher inhibitory effect on biofilm growth on glass rod than triclosan. In addition, thymol displayed the same antibacterial effect on Streptococcus mutans in poloxamer biofilm and hydroxyapatite biofilm as that of triclosan. Above findings indicate that the several biofilm models designed in this study are available for evaluation of novel anti-biofilm agent, suggesting that they could be applicable to develop oral care such as toothpaste and mouthrinse for inhibition of plaque biofilm.
Introduction
The networks of multiple synergistic and antagonistic interactions generate microbial inter-dependencies and give biofilms a resilience to minor environmental perturbations, and this contributes to oral health [1]. Bacteria are aggregated in a hydrated polymeric matrix of their own synthesis to form biofilm on surfaces. These sessile bacteria release antigens and stimulate the production of antibodies, but the antibodies are not effective in killing bacteria in biofilms and may cause immune complex damage to surrounding tissues, thus leading to any persistent and chronic bacterial infections [2]. In particular, oral bacteria in saliva form biofilms on hard tooth surfaces and dental materials [3]. The plaque that plays a key role in development of caries and periodontal disease is a kind of biofilm that contains oral saliva proteins adsorbed to cementum of and dentin of teeth, dextran and oral bacteria such as Streptococcus and Actinomyces. As time passes, this plaque is changed into calculus by adsorption of calcium and phosphorus in saliva, at the same time these bacteria in biofilm produce organic acids that dissolve enamel and dentin, eventually leading to development of caries. Therefore, in order to prevent the formation of biofilm composed of biopolymer such as plaque produced by bacteria, a number of antibacterial agents have been developed and applied to mouthwash and toothpaste. Quaternary Ammonium Compounds (QACs) have been known as one of the most visible and effective classes of disinfectants, leading to cell lysis and bacterial death [4]. In recent years, octenidine-containing mouthrinse showed the effective antibacterial and antiplaque effects on inhibition of oral cavity [5]. In addition, the mouthwash containing chitosan is capable of inhibiting all microorganisms’ adherence, biofilm formation and mature biofilms, providing a possibility that it has a great potential as a natural and efficient alternative to traditional mouthwashes [6]. In screening for antibacterial and anti-biofilm agents from medicinal plant extracts against oral microorganisms, the major constituent of Piper betle extract, 4-chromanol that has was identified as an antibacterial and anti-biofilm agent against oral pathogens for prevention of oral diseases [7]. In the most recent study, the combination of natural compounds such as carvacrol, thymol and eugenol with antibiotics enhances bacterial susceptibility and ameliorates eradication of biofilm formed by S. typhimurium on polystyrene micro plates [8]. However, it is impossible until now that antibacterial agents contained in mouthrinse completely remove the biofilm on tooth surface. Therefore, it is absolutely needed to develop a safe anti-biofilm agent capable of applying to mouthwash. The eugenol used in this study is contained in cloves, cinnamon and other aromatic spices which have been used as a supplement or a therapeutic ingredient in various medications and foods [9]. In particular, eugenol preconditioning may have a beneficial effect in the recovery of periodontal ligament from oxidative stress [10]. Therefore, we investigated whether essential oils can inhibit biofilm formation as well as antibacterial effect In Vitro. It was found that thymol exerts the inhibitory effect on biofilm formed by oral bacteria. Furthermore, this study evaluated a more appropriate method for testing antimicrobial efficacy of several essential oils on biofilms composed of several biopolymers compared with general antimicrobial agents.
Materials and Methods
Materials and Growth conditions
C57 BL/6 mice (n = 10 each group) were treated according to procedures approved by the Institutional Review Board (IRB) and ethical committee of the XXX.
Todd Hewitt Broth (THB) and agar were obtained from Gibco BRL, Life Technologies (USA). Streptococcus mutans 10449 were obtained from American Type of Culture Collection (Manassas, VA, USA). Sucrose, essential oils, 2, 3, 5-Triphenyltetrazolium Chloride (TTC) and other materials were purchased from Sigma Chemical Co. (St. Louis, MO, USA). The bacteria were maintained on Todd Hewitt Broth (THB) agar plates at 4℃ For biofilm studies, bacteria from several colonies were inoculated into test tubes containing 3 mL of THB and cultured overnight with shaking at 37℃ and used for further studies.
Antibacterial test for 1 m of exposure
In order to screen a new anti-plaque agent, the antibacterial effect of essential oils with penetration was investigated in this study. Streptococcus mutans was exposed to 4 kinds of essential oils containing thymol, eugenol, geraniol and clove oil at 100 μg/ mL for 1 m of short time. The bacteria were smeared on agar medium and incubated at 37℃ for 48h. Their antibacterial effect of essential oils was compared with triclosan used as a positive control by observation of colony formation.
Formation of dextran biofilm
Streptococcus mutans was incubated in Todd Hewitt Broth (THB) medium containing 1% sucrose for 48h. After centrifugation at 6,000 xg for 30 m, natural dextran was collected from pellet. And then, 26 mL of 2% liquid agar in THB medium was prepared using autoclave and mixed with above natural dextran, 3mL of 2.5% mucin, 1 mL overnight culture broth of Streptococcus mutans and 1 mL of 0.4% 2, 3, 5-Triphenyltetrazolium Chloride (TTC). Next, they were transferred into 24-well plate by 0.5 mL/ well and incubated at 37℃ for solidification. Thus, an artificial dextran biofilm was prepared and was exposed to 100 μL of the indicated doses of essential oils for 1 m for their penetration into biofilm. After that, the remaining essential oils was removed and the 24-well was incubated for 48 h at 37℃ to observe the bacterial growth visualized by AlphaEase®gel image analysis software (Alpha Inno Tech, CA, USA). The anti-biofilm effect of essential oils was quantified as a percentage compared to the blank group (density of cell growth in essential oils-treated biofilm / density of cell growth in f intact biofilm ×100).
Formation of poloxamer biofilm
Nonpolar poloxamer biofilm was prepared with 30% Di-block copolymer (poloxamer F127) composed of polyoxyethylene and polyoxypropylene. After 1mL of overnight culture broth of Streptococcus mutans was mixed with the biofilm containing 1% sucrose and 0.4% 2, 3, 5-Triphenyltetrazolium Chloride (TTC), it was transferred into 24-well plate by 1mL/well and incubated for 3 h at 4℃ for solidification. The biofilm was exposed to 100 μL of the indicated doses of essential oils for 1 m for their penetration into biofilm. After that, the remaining essential oils was removed and the 24-well was incubated for 48 h at 37℃ to observe the bacterial growth visualized by AlphaEase®gel image analysis software (Alpha Innotech, CA, US). The anti-biofilm effect of essential oils was quantified as a percentage compared to the blank group (density of cell growth in essential oils-treated biofilm / density of cell growth in f intact biofilm ×100).
Formation of dextran biofilm adhered to glass rod
Dextran biofilm adhered to glass rod was prepared using glass rod with 7 Cm in length and 0.5 Cm in diameter. For the growth of Streptococcus mutans in dextran biofilm adhered to glass rod which put in test tube containing 1% sucrose and THB medium, they were incubated for 48 h. Then, after the glass rods were taken out of each test tube, they were exposed to the indicated doses of triclosan and thymol for 1 m and transferred into THB medium containing Streptococcus mutans and TTC to observe the bacterial growth visualized by AlphaEase®gel image analysis software (Alpha Innotech, CA, US). The anti-biofilm effect of essential oils was quantified as a percentage compared to the blank group (density of cell growth in essential oils-treated biofilm / density of cell growth in f intact biofilm ×100).
Formation of natural biofilm adhered to hydroxyapatite
Natural biofilm adhered to hydroxyapatite was prepared using hydroxyapatite disk with 0.1 Cm in thickness and 1.2 Cm in diameter. First of all, hydroxyapatite disk was manufactured using tablet machine. It was transferred into each well of 24-well plate and incubated in solution containing Streptococcus mutans, 1% sucrose, THB medium and artificial saliva at pH 6.8 containing 0.381 g NaCl, 0.213 g CaCl2·2H2O, 1.114 g KCl, 0.738 g KH2PO4, and 2.2 g mucin in 1000 ml distilled water for 48 h to adhere biofilm to hydroxyapatite disk. Then, after the hydroxyapatite disks were taken out of each well, they were exposed to essential oils for 1 m and transferred into THB medium containing Streptococcus mutans and TTC to observe the bacterial growth visualized by AlphaEase®gel image analysis software (Alpha Innotech, CA, US). The anti-biofilm effect of essential oils was quantified as a percentage compared to the blank group (density of cell growth in essential oils-treated biofilm / density of cell growth in f intact biofilm ×100).
Statistics
Data were analyzed using Student’s test for paired data (comparison with control group) and eugenol. Data are given as means of values ± S.D. from three independent experiments (* P < 0.05, ** P < 0.01, *** P < 0.001).
Results
Antibacterial effect of essential oils for 1 m of exposure
In order to screen a new anti-plaque agent, the antibacterial effect of essential oils with penetration and cleaning power was investigated in this study. S. mutans were exposed to 4 kinds of essential oils containing thymol, eugenol, geraniol and clove oil at 100 μg/ mL for 1 m of short time. Their antibacterial effect was compared with triclosan used as a positive control. As shown in figure 1, triclosan at 100 μg/ mL completely inhibited the growth of Streptococcus mutans compared with blank group. Among essential oils, thymol, eugenol and clove oil showed 50% of antibacterial effect compared with blank group.
Figure 1: Antibacterial effects of essential oils for 1 m of exposure. Streptococcus mutans were exposed to 4 kinds of essential oils containing thymol, eugenol, geraniol and clove oil at 100 μg/ mL for 1 m. Blank group (A), and the antibacterial effects of essential oils such as geraniol (B), eugenol (C), clove oil (D) and thymol (E) were compared with triclosan (F) used as a positive control.
Figure 1: Antibacterial effects of essential oils for 1 m of exposure. Streptococcus mutans were exposed to 4 kinds of essential oils containing thymol, eugenol, geraniol and clove oil at 100 μg/ mL for 1 m. Blank group (A), and the antibacterial effects of essential oils such as geraniol (B), eugenol (C), clove oil (D) and thymol (E) were compared with triclosan (F) used as a positive control.
Antibacterial effect of essential oils on Streptococcus mutans in dextran biofilm
In a subsequent experiment, the antibacterial effect of 21 essential oils at 1,000 μg/ mL on S. mutans in dextran biofilm was investigated in this experiment. In order to prepare an artificial dextran biofilm, S. mutans were incubated in Todd Hewitt Broth (THB) medium containing 1% sucrose for 48h. After centrifugation, natural dextran was collected from pellet. And then, it was mixed with liquid agar, mucin, THB medium and TTC. Next, they were inoculated into 24-well plate incubated at 37℃ for solidification. The biofilm was exposed to 500 μg/ mL of essential oils for 1 m for their penetration into biofilm. After that, the remaining essential oils was removed and the 24-well was incubated for 48 h at 37℃ to observe the bacterial growth. As shown in figure 2, it was observed that eugenol and clove oil among these essential oils showed the highest antibacterial effect on S. mutans in dextran biofilm compared with triclosan used as a positive control. This result indicates that eugenol and clove oil have the excellent penetrative effect into dextran film.
 Figure 2: Antibacterial effect of essential oils on Streptococcus mutans in dextran biofilm. The antibacterial effects of 21 kinds of essential oils at 500 μg/ mL on Streptococcus mutans in dextran biofilm were evaluated in this experiment. The biofilm was exposed to 1,000 μg/ mL of essential oils for 1 m for their penetration into biofilm. 21 kinds of essential oils are as follows: 1. Alpha- Pinene, 2. Basil, 3. Citronella, 4. 1, 8-Cineole, 5. .Clove, 6. p-Cymene, 7. Eucalyptus, 8. Eugenol, 9. Geraniol, 10. Geranium, 11. Geranyl acetate, 12. Helichrysum, 13. Isobornyl acetate, 14. Linalool, 15. Neryl acetate, 16. Nonanal, 17. Patchouli, 18. Thume, 19. Dodecanal, 20. Camphor, 21. Borneol, 22. Thymol, 23. Triclosan, 24. Blank. Lower panel represents respective relative protein percentage compared to the blank group (density of cell growth in essential oils-treated biofilm / density of cell growth in f intact biofilm ×100). Data are given as means of values ± S.D. from three independent experiments compared with control (* P < 0.05, ** P < 0.01, *** P < 0.001).
Figure 2: Antibacterial effect of essential oils on Streptococcus mutans in dextran biofilm. The antibacterial effects of 21 kinds of essential oils at 500 μg/ mL on Streptococcus mutans in dextran biofilm were evaluated in this experiment. The biofilm was exposed to 1,000 μg/ mL of essential oils for 1 m for their penetration into biofilm. 21 kinds of essential oils are as follows: 1. Alpha- Pinene, 2. Basil, 3. Citronella, 4. 1, 8-Cineole, 5. .Clove, 6. p-Cymene, 7. Eucalyptus, 8. Eugenol, 9. Geraniol, 10. Geranium, 11. Geranyl acetate, 12. Helichrysum, 13. Isobornyl acetate, 14. Linalool, 15. Neryl acetate, 16. Nonanal, 17. Patchouli, 18. Thume, 19. Dodecanal, 20. Camphor, 21. Borneol, 22. Thymol, 23. Triclosan, 24. Blank. Lower panel represents respective relative protein percentage compared to the blank group (density of cell growth in essential oils-treated biofilm / density of cell growth in f intact biofilm ×100). Data are given as means of values ± S.D. from three independent experiments compared with control (* P < 0.05, ** P < 0.01, *** P < 0.001).
Antibacterial effect of essential oils on Streptococcus mutans in poloxamer biofilm
In this study, in order to investigate whether essential oils inhibit the growth Streptococcus mutans in biofilm, Di-block copolymer (poloxamer F127) composed of polyoxyethylene and polyoxypropylene was used to prepare nonpolar poloxamer biofilm. After 1mL of overnight culture fluid of S. mutans was mixed with the biofilm containing 1% sucrose and TTC, they were inoculated into 24-well plate incubated for 3 h at 4℃ for solidification. The biofilm was exposed to the indicated doses of essential oils for 1 m for its penetration into biofilm. After that, the remaining essential oils was removed and the 24-well was incubated for 48 h at 37℃ to observe the bacterial growth. As shown in figure 3, triclosan used as a positive control showed the antibacterial effect at 20, 000 μg/ mL on S. mutans in nonpolar poloxamer biofilm. However, cetylpyridium chloride (CPC) showed the antibacterial effect at 50, 000 μg/mL on S. mutans in nonpolar poloxamer biofilm. Thymol displayed the antibacterial effect at 20, 000 μg/ mL similar to that of triclosan on S. mutans in nonpolar poloxamer biofilm. This result indicates that the essential oils could easily penetrate into nonpolar poloxamer biofilm and exert the same antibacterial effect as triclosan.
 Figure 3: Antibacterial effect of essential oils on Streptococcus mutans in dextran biofilm. The antibacterial effects of 21 kinds of essential oils at 500 μg/ mL on Streptococcus mutans in dextran biofilm were evaluated in this experiment. The biofilm was exposed to 1,000 μg/ mL of essential oils for 1 m for their penetration into biofilm. 21 kinds of essential oils are as follows: 1. Alpha- Pinene, 2. Basil, 3. Citronella, 4. 1, 8-Cineole, 5. .Clove, 6. p-Cymene, 7. Eucalyptus, 8. Eugenol, 9. Geraniol, 10. Geranium, 11. Geranyl acetate, 12. Helichrysum, 13. Isobornyl acetate, 14. Linalool, 15. Neryl acetate, 16. Nonanal, 17. Patchouli, 18. Thume, 19. Dodecanal, 20. Camphor, 21. Borneol, 22. Thymol, 23. Triclosan, 24. Blank. Lower panel represents respective relative protein percentage compared to the blank group (density of cell growth in essential oils-treated biofilm / density of cell growth in f intact biofilm ×100). Data are given as means of values ± S.D. from three independent experiments compared with control (* P < 0.05, ** P < 0.01, *** P < 0.001).
Figure 3: Antibacterial effect of essential oils on Streptococcus mutans in dextran biofilm. The antibacterial effects of 21 kinds of essential oils at 500 μg/ mL on Streptococcus mutans in dextran biofilm were evaluated in this experiment. The biofilm was exposed to 1,000 μg/ mL of essential oils for 1 m for their penetration into biofilm. 21 kinds of essential oils are as follows: 1. Alpha- Pinene, 2. Basil, 3. Citronella, 4. 1, 8-Cineole, 5. .Clove, 6. p-Cymene, 7. Eucalyptus, 8. Eugenol, 9. Geraniol, 10. Geranium, 11. Geranyl acetate, 12. Helichrysum, 13. Isobornyl acetate, 14. Linalool, 15. Neryl acetate, 16. Nonanal, 17. Patchouli, 18. Thume, 19. Dodecanal, 20. Camphor, 21. Borneol, 22. Thymol, 23. Triclosan, 24. Blank. Lower panel represents respective relative protein percentage compared to the blank group (density of cell growth in essential oils-treated biofilm / density of cell growth in f intact biofilm ×100). Data are given as means of values ± S.D. from three independent experiments compared with control (* P < 0.05, ** P < 0.01, *** P < 0.001).
Antibacterial effect of essential oils on Streptococcus mutans in dextran biofilm adhered to glass rod
In next experiment, the antibacterial effect of essential oils on S. mutans in dextran biofilm adhered to glass rod was investigated. For the growth of S. mutans in dextran biofilm adhered to glass rod which put in test tube containing 1% sucrose and THB medium, they were incubated for 48 h. After the glass rods were taken out of each test tube, they were exposed to the indicated doses of triclosan and thymol for 1 m and transferred into THB medium containing S. mutans and TTC to observe the bacterial growth visually. As shown in figure 4, triclosan used as a positive control showed the antibacterial effect at 10,000 μg/ mL on S. mutans in dextran biofilm on glass rod. However, thymol at 1,000 μg/ mL showed the antibacterial effect on S. mutans in dextran biofilm on glass rod. This result indicates that thymol could exert a higher antibacterial effect than triclosan on S. mutans in dextran biofilm on glass rod.
 Figure 4: Antibacterial effect of essential oils on Streptococcus mutans in dextran biofilm adhered to glass rod. The antibacterial effects of essential oils on bacteria in dextran biofilm adhered to glass rod were evaluated in this experiment. The biofilm was exposed to the indicated doses of triclosan used as a positive control and thymol for 1 m and transferred into THB medium containing Streptococcus mutans and TTC to observe the bacterial growth. Lower panel represents respective relative protein percentage compared to the blank group (density of cell growth in essential oils-treated biofilm / density of cell growth in f intact biofilm ×100). Data are given as means of values ± S.D. from three independent experiments compared with control (* P < 0.05, ** P < 0.01, *** P < 0.001).
Figure 4: Antibacterial effect of essential oils on Streptococcus mutans in dextran biofilm adhered to glass rod. The antibacterial effects of essential oils on bacteria in dextran biofilm adhered to glass rod were evaluated in this experiment. The biofilm was exposed to the indicated doses of triclosan used as a positive control and thymol for 1 m and transferred into THB medium containing Streptococcus mutans and TTC to observe the bacterial growth. Lower panel represents respective relative protein percentage compared to the blank group (density of cell growth in essential oils-treated biofilm / density of cell growth in f intact biofilm ×100). Data are given as means of values ± S.D. from three independent experiments compared with control (* P < 0.05, ** P < 0.01, *** P < 0.001).
Antibacterial effect of essential oils on Streptococcus mutans in natural biofilm adhered to hydroxyapatite
In order to confirm the antibacterial effect of essential oils on S. mutans in natural biofilm, hydroxyapatite disks composed of teeth ingredients were manufactured using tablet machine. They were transferred into each well of 24-well plate, and incubated in solution containing Streptococcus mutans, 1% sucrose, THB medium and artificial saliva for 48 h to adhere biofilm to hydroxyapatite disk. After the hydroxyapatite disks were taken out of each well, they were exposed to essential oils for 1 m and transferred into THB medium containing S. mutans and TTC to observe the bacterial growth visually. As shown in figure 5, triclosan used as a positive control showed the antibacterial effect at 1,000 μg/mL on S. mutans in biofilm on hydroxyapatite disk. Eugenol and clove oil displayed the antibacterial effect at 10,000 μg/mL on S. mutans in biofilm on hydroxyapatite disk. However, thymol at 1,000 μg/ mL showed the same antibacterial effect on S. mutans in biofilm on hydroxyapatite disk as triclosan. This result indicates that thymol could exert a similar antibacterial effect to triclosan on Streptococcus mutans in natural biofilm.
 Figure 5: Antibacterial effect of essential oils on Streptococcus mutans in natural biofilm adhered to hydroxyapatite. The antibacterial effects of essential oils on Streptococcus mutans in natural biofilm on hydroxyapatite disk were evaluated in this experiment. The biofilm was exposed to essential oils for 1 m and transferred into THB medium containing Streptococcus mutans and TTC to observe the bacterial growth and compared with that of triclosan used as a positive control. Lower panel represents respective relative protein percentage compared to the blank group (density of cell growth in essential oils-treated biofilm / density of cell growth in f intact biofilm ×100). Data are given as means of values ± S.D. from three independent experiments compared with control (* P < 0.05, ** P < 0.01, *** P < 0.001).
Figure 5: Antibacterial effect of essential oils on Streptococcus mutans in natural biofilm adhered to hydroxyapatite. The antibacterial effects of essential oils on Streptococcus mutans in natural biofilm on hydroxyapatite disk were evaluated in this experiment. The biofilm was exposed to essential oils for 1 m and transferred into THB medium containing Streptococcus mutans and TTC to observe the bacterial growth and compared with that of triclosan used as a positive control. Lower panel represents respective relative protein percentage compared to the blank group (density of cell growth in essential oils-treated biofilm / density of cell growth in f intact biofilm ×100). Data are given as means of values ± S.D. from three independent experiments compared with control (* P < 0.05, ** P < 0.01, *** P < 0.001).
Discussion
Dental plaque is a kind of a biofilm that contains oral microorganisms and dextran and prevents host from invading pathogenic bacteria. However, once oral homeostasis breaks down under certain stress, caries or periodontal disease can occur. In dental caries, acid-producing bacteria such as S. streptococci and Lactobacilli are predominant and prefer an acidic pH to a neutral pH for growth, leading to demineralization of enamel and dentin. The best strategy to control caries is to reduce biofilm development. Although a variety of antibacterial have been developed to control bacterial growth until now, it is still impossible to eradicate biofilm such as plaque because of their poor penetration ability into plaque, leading to let bacteria in plaque survivable. Therefore, it is necessary to screen anti-biofilm agents to solve those problems.
This study is to investigate the effect of essential oils on bacteria growth in plaque using several biofilm models. First of all, various kinds of biofilm simulating a natural oral biofilm were designed using glass rod and hydroxyapatite. The effects of essential oils with hydrophobic property such as thymol, eugenol and clove oil on biofilm growth proceeded by Streptococcus mutans were compared with that of triclosan. In order to screen a new anti-plaque agent, the antibacterial effect of essential oils with penetration and cleaning power was investigated in this study. S. mutans were exposed to 4 kinds of essential oils containing thymol, eugenol, geraniol and clove oil in short time. Among essential oils, thymol, eugenol and clove oil showed a lower antibacterial effect than triclosan used as a positive control. The previous study reported that essential oils exert an antibiotic effect and the usefulness of mixture design in the estimation of antibacterial interaction [8,12]. In the next study, an artificial dextran biofilm was designed using S. mutans, sucrose, agar and mucin to investigate the antibacterial effect of essential oils on S. mutans in dextran biofilm. It was observed that eugenol and clove oil among these essential oils showed the highest antibacterial effect on S. mutans in dextran biofilm compared with triclosan used as a positive control. This result indicates that eugenol and clove oil have the excellent penetrative effect into dextran film consistent with the previous report that they display anti-biofilm activity [13,14]. Subsequently, the second nonpolar poloxamer biofilm was designed using Di-block copolymer composed of polyoxyethylene and polyoxypropylene with S. mutans and sucrose to investigate whether essential oils inhibit the growth S. mutans in the biofilm. Triclosan used as a positive control showed the antibacterial effect at high concentration in nonpolar poloxamer biofilm as reported by the previous study that the sutures coated with triclosan and chlorohexidine have a promising potential in preventing the colonization of periodontal pathogens around it, thereby inhibiting biofilm formation [15]. However, cetylpyridium chloride (CPC) showed the antibacterial effect at a higher dose than triclosan in nonpolar poloxamer biofilm. This result suggests that it is difficult for cationic antibacterial agents to penetrate into biofilm. Thymol displayed the antibacterial effect at dose similar to that of triclosan in nonpolar poloxamer biofilm. The previous study reported that thymol displays antifungal activity as a nonpolar antimicrobial agent [16]. This result suggests that thymol could penetrate into nonpolar poloxamer biofilm and exert the same antibacterial effect. The third biofilm was designed using S. mutans in dextran biofilm adhered to glass rod to investigate whether essential oils exert the antibacterial effect of essential oils on bacteria in it. Thymol exerted higher antibacterial effect than triclosan in dextran biofilm on glass rod. This result means that the anti-biofilm activity of essential oils could be displayed depending on the nature of biofilm. The last biofilm was designed using S. mutans in natural biofilm adhered to hydroxyapatite used for study of periodontal disease In vitro [17]. Triclosan used as a positive control showed the higher antibacterial effect in biofilm on hydroxyapatite disk than eugenol and clove oil. However, thymol showed a similar antibacterial effect in biofilm to hydroxyapatite disk to triclosan. The previous study reported that thymol is efficient in reducing the biofilm biomass [18]. This result suggests that thymol among essential oils could exert a similar antibacterial effect to triclosan on S. mutans in natural biofilm.
In conclusions, although essential oils exert a lower antibacterial effect than general antibacterial agents, essential oils with nonpolar property could display a higher anti-biofilm activity than them. In particular, our finding from the assays using several kinds of biofilm model suggests that thymol could be available in inhibition of plaque for prevention of caries and periodontal disease as a potential agent against biofilm. In particular, among essential oils thymol has the same inhibitory effect as triclosan used in commercial toothpaste that exerts a substantive effect on plaque. Therefore, above findings indicate that the several biofilm models designed in this study are available for evaluation of novel anti-biofilm agent, suggesting that they could be applicable to development of oral care such as tooth paste and mouthrinse for the inhibition of plaque biofilm.
References
- Marsh PD, Zaura E. Dental biofilm: Ecological interactions in health and disease. J Clin Periodontol. 2017; 44: 12-22. https://goo.gl/PMdGAA
- Costerton JW, Stewart PS, Greenberg EP. Bacterial biofilms: A common cause of persistent infections. Science. 1999; 284: 1318-1322. https://goo.gl/iTks9V
- Wang Z, Shen Y, Haapasalo M. Dental materials with antibiofilm properties. Dent Mater. 2014; 30: 1-16. https://goo.gl/bEFUpG
- Jennings MC, Minbiole KP, Wuest WM. Quaternary ammonium compounds: an antimicrobial mainstay and platform for innovation to address bacterial resistance. ACS Infect Dis. 2015; 1: 288-303. https://goo.gl/p2AkfK
- Welk A, Zahedani M, Beyer C, Kramer A, Müller G. Antibacterial and antiplaque efficacy of a commercially available octenidine-containing mouthrinse. Clin Oral Investig. 2015; 2: 1-8. https://goo.gl/K9Qc79
- Costa EM, Silva S, Madureira AR, Cardelle Cobas A, Tavaria FK, Pintado MM. A comprehensive study into the impact of a chitosan mouthwash upon oral microorganism's biofilm formation in vitro. Carbohydr Polym. 2014; 101: 1081-1086. https://goo.gl/KQwcWr
- Teanpaisan R, Kawsud P, Pahumunto N, Puripattanavong J. Screening for antibacterial and antibiofilm activity in Thai medicinal plant extracts against oral microorganisms. J Tradit Complement Med. 2016; 7: 172-177. https://goo.gl/wvQYkf
- Miladi H, Zmantar T, Kouidhi B, Chaabouni Y, Mahdouani K, Bakhrouf A, et al. Use of carvacrol, thymol, and eugenol for biofilm eradication and resistance modifying susceptibility of Salmonella enterica serovar Typhimurium strains to nalidixic acid. Microb Pathog. 2017; 104: 56-63. https://goo.gl/35mv6g
- Yoo CB, Han KT, Cho KS, Ha J, Park HJ, Nam JH, et al. Eugenol isolated from the essential oil of Eugenia caryophyllata induces a reactive oxygen species-mediated apoptosis in HL-60 human promyelocytic leukemia cells. Cancer Lett. 2005; 225: 41-52. https://goo.gl/dNgwYo
- Yong-Ho Kim and Bong-Soo Park. Antioxidant Effect of Eugenol in Human Periodontal Ligament Fibroblasts. Korean J Phys Anthropol. 2015; 28: 45-53. https://goo.gl/3Y5ddH
- Knezevic P, Aleksic V, Simin N, Svircev E, Petrovic A, Mimica-Dukic N. Antimicrobial activity of Eucalyptus camaldulensis essential oils and their interactions with conventional antimicrobial agents against multi-drug resistant Acinetobacter baumannii. J Ethnopharmacol. 2016; 178: 125-136. https://goo.gl/EoCGdN
- Ouedrhiri W, Balouiri M, Greche H, Moja S, Chahdi F.O, Taleb M, et al. Mixture design of Origanum compactum, Origanum majorana and Thymus serpyllum essential oils: Optimization of their antibacterial effect. Industrial Crops and Products. 2016; 89: 1-9. https://goo.gl/y4f5ck
- Cui H, Ma C, and Lin L. Synergetic antibacterial efficacy of cold nitrogen plasma and clove oil against Escherichia coli O157: H7 biofilms on lettuce. Food Control. 2016; 66: 8-16. https://goo.gl/QWHwQv
- Kim YG, Lee JH, Gwon G, Kim SI, Park JG, Lee J. Essential Oils and Eugenols Inhibit Biofilm Formation and the Virulence of Escherichia coli O157: H7. Sci Rep. 2016; 6: 36377. https://goo.gl/eLbvKv
- Sethi KS, Karde PA, Joshi CP. Comparative evaluation of sutures coated with triclosan and chlorhexidine for oral biofilm inhibition potential and antimicrobial activity against periodontal pathogens: An in vitro study. Indian J Dent Res. 2016; 27: 535. https://goo.gl/rd9hfM
- Marchese A, Orhan IE, Daglia M, Barbieri R, Di Lorenzo A, Nabavi SF. Antibacterial and antifungal activities of thymol: a brief review of the literature. Food Chem. 2016; 210: 402-414. https://goo.gl/1nj6sb
- Jaffar N, Miyazaki T, Maeda T. Biofilm formation of periodontal pathogens on hydroxyapatite surfaces: Implications for periodontium damage. J Biomed Mater Res A. 2016; 104: 2873-2880. https://goo.gl/FnBwXe
- Verardi G, Cenci MS, Maske TT, Webber B, Santos LR. Antiseptics and microcosm biofilm formation on titanium surfaces. Braz Oral Res. 2016; 30: https://goo.gl/efz5pj
Authors submit all Proposals and manuscripts via Electronic Form!




























